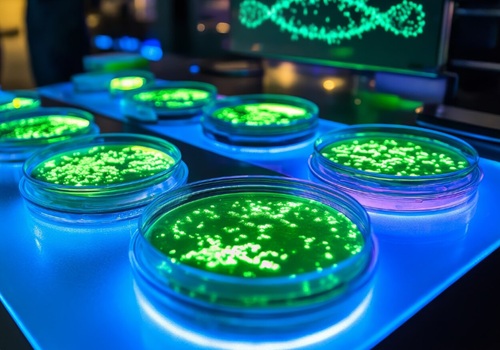
#

Methyl 2,4-dihydroxy-6-Butylbenzoate( CAS No.102342-62-1) is a synthetic alkylresorcinol derivative characterized by a 1,3-dihydroxybenzene (resorcinol) core substituted with an n-butyl chain at the 6-position and a methyl ester group. This structure combines phenolic reactivity, lipophilicity, and functional versatility, making it a valuable intermediate in organic synthesis and pharmaceutical research.
Name :
Methyl 2,4-dihydroxy-6-ButylbenzoateCAS No. :
102342-62-1MF :
C₁₂H₁₆O₄MW :
224.25Purity :
98%Appearance :
White to off-white crystalline solid or viscous oil (depending on purity)Storage Condition :
Store in a cool, dry place under inert atmosphere (nitrogen/argon) at 2–8°C
Chemical Properties
CAS Number: 102342-62-1
IUPAC/Chemical Name:Methyl 2,4-dihydroxy-6-Butylbenzoate
Synonym: 2,4-dihydroxy-6-n-butylbenzoic acid, methyl ester;2,4-dihydroxy-6-n-butylbenzoic acid, methyl ester;Benzoic acid, 2-butyl-4,6-dihydroxy-, methyl ester;2,4-dihydroxy-6-n-butylbenzoic acid
Molecular Formula: C₁₂H₁₆O₄
Molecular Weight: 224.25 g/mol
Appearance: White to off-white crystalline solid or viscous oil (depending on purity)
Melting Point: ~69°C (predicted)
Boiling Point: 388.6 ± 27.0°C (predicted)
Density: 1.180 ± 0.06 g/cm³ (predicted)
pKa: 8.27 ± 0.23 (predicted)
SMILES Notation: C(OC)(O)C1C(O)CC(O)CC1CCCC
InChI: InChI=1S/C12H16O4/c1-3-4-5-8-6-9(13)7-10(14)11(8)12(15)16-2/h6-7,13-14H,3-5H2,1-2H3
Solubility: Soluble in organic solvents (e.g., methanol, ethanol, DMSO, ethyl acetate); insoluble in water due to hydrophobic alkyl chain.
Structural Attributes:
Bioactive resorcinol scaffold with two phenolic hydroxyl groups (positions 2 and 4), enabling hydrogen bonding and electrophilic substitution.
n-Butyl chain (linear C₄ alkyl group) enhancing lipid solubility and modulating biological interactions.
Methyl ester group providing a site for hydrolysis or further functionalization.
Synthesis and Production
Synthesis Pathway:
Alkylation: Introduce n-butyl chain via Friedel-Crafts alkylation using n-butyl bromide and AlCl₃.
Hydroxylation: Install hydroxyl groups at positions 2 and 4 using oxidative agents (e.g., BBr₃).
Esterification: React 2,4-dihydroxy-6-n-butylbenzoic acid with methanol in the presence of H₂SO₄
Applications

Safety and Handling
Hazard Profile: Potential irritant (skin/eyes/respiratory tract) due to phenolic nature.
Precautions:
Use in a well-ventilated area (e.g., fume hood).
Wear appropriate PPE (gloves, safety glasses, lab coat).
Avoid dust inhalation and direct contact.
Storage: Store in a cool, dry place in a tightly sealed container protected from light.
FAQ
Q:What's the Key Advantages for Research about CAS 102342-62-1?
A:There are three advantages about CAS 102342-62-1
•Structural Precision: Defined alkyl chain length (n-butyl) ensures consistency in bioactivity studies.
•Synthetic Flexibility: Multiple reactive sites allow selective modifications for tailored applications.
•Research-Grade Quality: Ideal for medicinal chemistry, material science, and analytical standardization.
Q:What are the shipping and storage conditions?
A: It is essential to consider the following factors:
•Temperature control: Ambient / -20°C refrigerated
•Hazard classification: UN number (e.g., UN 3077)
•Regional restrictions (e.g., not shippable to USA)
Q:Can you provide certified documentation?
A:Document Checklist:
•Certificate of Analysis (CoA) with test methods (e.g., HPLC chromatogram)
•Safety Data Sheet (SDS) compliant with GHS Rev.10
Q:Which aspects need to be considered when purchasing this compound?
A: When purchasing this compound, it is essential to consider the following factors:
•Suppliers: Specialized fine chemical vendors (e.g., Tokyo Chemical Industry (TCI), Santa Cruz Biotechnology, BOC Sciences), and custom synthesis providers.
•Packaging: Available in research-scale quantities (e.g., 100 mg to 100 g); larger volumes require custom synthesis.
•Purity: Typically ≥95% or ≥97% (verified by HPLC/NMR).
•Documentation: Suppliers provide Certificate of Analysis (CoA) and Safety Data Sheet (SDS) upon request.
Q: What is the primary research application of this compound?
A: This compound serves as a key synthetic intermediate in medicinal chemistry, particularly for developing cannabinoid analogs with modified alkyl chains. The butyl (C4) chain length is valuable for studying structure-activity relationships and optimizing receptor binding selectivity.
Q: Why choose the butyl chain derivative over other alkyl lengths?
A: The n-butyl chain (C4):
•Offers intermediate lipophilicity (log P ~3.8)
•Provides optimal steric properties for certain receptor subtypes
•Enables precise SAR studies between propyl (C3) and pentyl (C5) analogs
•Improves crystallization behavior for easier purification
Q: What purity specifications do you offer?
A: We provide:
•Standard Grade: ≥97% (HPLC)
•High Purity Grade: ≥99% (HPLC with NMR confirmation)
All batches include comprehensive Certificate of Analysis with impurity profiling.
Q: How does the methyl ester enhance stability?
A: The methyl ester group:
•Prevents decarboxylation during storage and reactions
•Improves solubility in organic solvents
•Allows controlled hydrolysis to the free acid when needed
•Enhances shelf-life (>24 months at -20°C)
Q: Can you produce custom analogs with different chain lengths?
A: Yes. We specialize in:
•Alkyl chain modifications (C1-C12)
•Bulk quantities (up to kilogram scale)
•Custom ester derivatives (ethyl, propyl, butyl esters)
Contact us with your specific molecular requirements.
Q: Is this compound regulated?
A: This synthetic intermediate is not controlled under international narcotics conventions. However, customers should verify compliance with their local regulations regarding precursor compounds.
Q: What is the recommended storage condition?
A: Store in sealed containers under inert atmosphere at -20°C. Protect from light and moisture. Under these conditions, the compound remains stable for at least 24 months.
Q: What's the lead time for orders?
A: •Research quantities (≤25g): 1-2 weeks
•Bulk quantities (100g-1kg): 3-5 weeks
•Custom synthesis: 4-6 weeks
Leave A Message
Scan to Wechat/Whatsapp :

